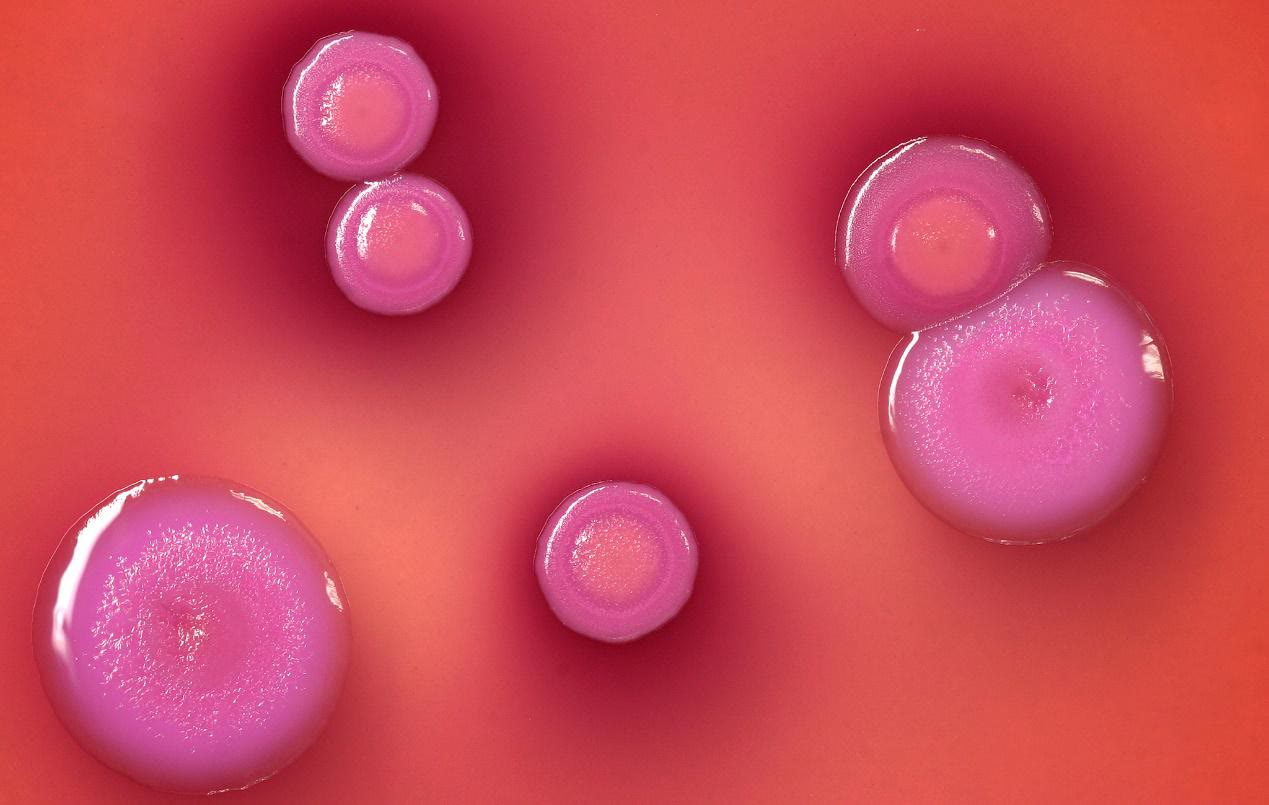
频繁挖鼻孔险丧命,长期挖鼻孔注意事项

生活中很多人都有挖鼻孔的习惯,而且有些人就算鼻腔里没有鼻屎,也会在无聊闲暇的时候也想抠一抠,觉得这样才舒服。长此以往,挖鼻孔就成为一种潜意识行为,不再受意识层面的管辖,而是由潜意识主导。有些人挖鼻孔的状态,已经到达了手不离鼻,甚至还会拔出他们的鼻毛和挖出鼻血。这种行为称为“强制性挖鼻综合症”。

经常挖鼻孔,要谨慎 2 大风险
1. 造成感染
鼻孔中有鼻粘膜,这些粘膜可以起到保护作用。在呼吸过程中,有助于吸收和过滤空气中的颗粒、灰尘等有害物质,避免进入人体引起疾病。但是经常用手挖鼻孔,锋利的指甲还会在挖鼻孔时刺激鼻粘膜,导致损伤粘膜,造成抵抗力下降,从而增加患鼻腔疾病的风险。而且经常挖鼻孔还会会加重鼻窦炎和鼻炎。
2.容易鼻出血
鼻粘膜充满毛细血管和一些腺体,它们随时分泌粘液以保持鼻腔湿润。如果经常用手挖鼻孔,由于手上带有细菌再加上手指甲很锋利,所以很容易损伤鼻粘膜,导致鼻粘膜损伤或出血,严重时甚至持续出血需要很长时间才能恢复。

挖鼻孔的习惯对我们的危害极大,如果你经常挖鼻孔,那可就要注意了。
减少“鼻子病”,科学清理鼻腔
1.专业洗鼻器清洗
专业洗鼻器搭配盐水洗鼻子主要是利用一定的压力将生理盐水送入鼻腔,流经鼻前庭、副鼻窦和鼻腔通道,通过鼻咽,或从一个鼻孔或口腔排出。通过上述途径,借助生理盐水的杀菌作用和水流的影响,帮助将鼻腔内积聚的各种病原污染物排出,从而恢复鼻腔正常健康的生理环境,恢复鼻腔的自我排毒功能,达到保护鼻腔的目的。

2.用棉签蘸取温水擦拭
清洁鼻孔时,使用棉签或纸巾可以有效防止感染,避免指甲划伤鼻腔引起的鼻腔粘膜炎症。用棉签清理时,可以先用温水把棉签弄湿,然后把水擦干,然后把它伸进鼻腔,慢慢地从鼻腔里带出污浊物。如果使用纸巾,则需要将其拧成小条,塞入鼻腔,然后缓慢旋转以拖出污物。不要用力过大,以免损坏鼻腔粘膜!

3 .专业医院清理
如果以上两种方式自己不好掌控,也可以到专业的医院来清理,这样子也可以在一定程度上减少由于错误操作导致的误伤。而且专业的医院,可以提供更安全的工具来帮助洗鼻,对鼻腔也有更好的保护作用。

找到了健康科学的洗鼻方法,那么,在日常生活中,也一定要控制住自己,减少用手挖鼻孔的次数,尽量做到不用手挖清理鼻孔。